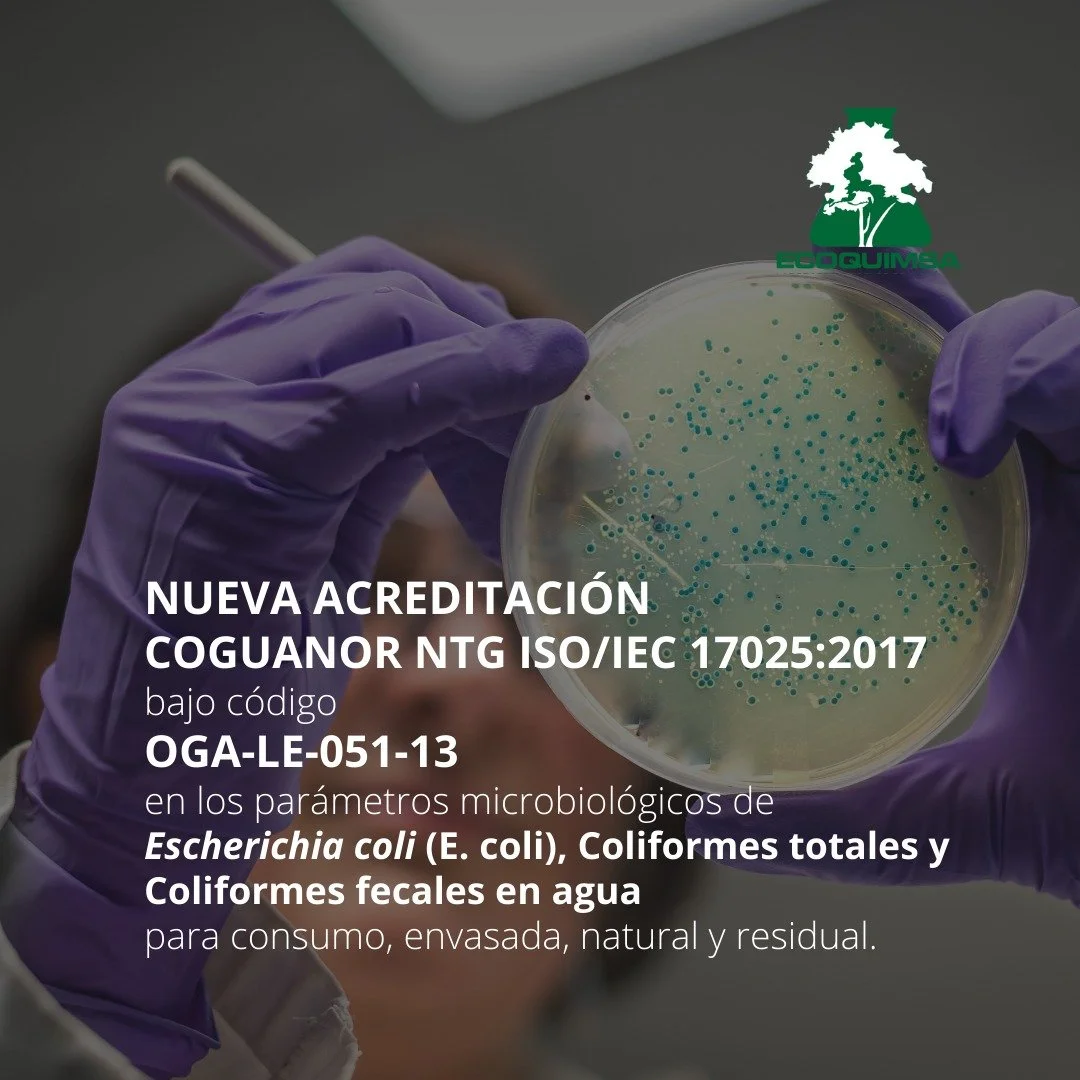
Acreditación COGUANOR NTG ISO/IEC 17025:2017

Microbiología: Parámetros acreditados 2022
Escrito por: Lucía Ruiz y el equipo de Laboratorio ECOQUIMSA
Hoy 24 de marzo del 2022, La Comunidad ECOQUIMSA, estamos muy felices de anunciarte que seguimos cumpliendo nuestros sueños. Obtuvimos la acreditación COGUANOR NTG ISO/IEC 17025:2017 bajo código OGA-LE-051-13 en los parámetros microbiológicos de Escherichia coli (E. coli), Coliformes totales y Coliformes fecales en agua para consumo, envasada, natural y residual.
Para conocer un poco más del tema de microbiología, necesitamos dos conceptos: Los patógenos, que son microorganismos que causan daño o enfermedades; y los microorganismos indicadores, que son microorganismos con características similares a los patógenos, pero con métodos de análisis más fáciles y económicos de realizar. La presencia de microorganismos indicadores puede estar relacionado a la presencia de patógenos en el agua, es decir: si hay presencia de indicadores, es muy probable que también haya patógenos.
Los indicadores más conocidos para calidad del agua son las bacterias del grupo coliforme. Entre estos tenemos los análisis de coliformes totales como indicadores de la eficiencia de procesos de limpieza y desinfección, y los análisis de coliformes fecales o termotolerantes que son indicadores de contaminación fecal. Adicional tenemos los análisis de Escherichia coli, una bacteria que actúa como patógeno y a su vez indicador de contaminación fecal, al ser un habitante común del tracto gastrointestinal.
Estos tres indicadores son analizados por el método de Número Más Probable (NMP), el cual permite hacer una estimación de la cantidad de bacterias en un volumen de 100 mililitros, por medio de la inoculación de la muestra en tubos con medio de cultivo. También es importante resaltar que estos se encuentran acreditados bajo COGUANOR NTG ISO/IEC 17025:2017 bajo código OGA-LE-051-13.
Las muestras destinadas a dichos análisis deben ser tomadas en una bolsa con cierre hermético o frascos estériles para evitar cualquier contaminación externa. Adicional se debe tomar en cuenta los niveles de cloro en la muestra, por lo cual, de ser necesario, se debe usar el reactivo Tiosulfato de Sodio para neutralizar el cloro y así evitar un falso negativo.